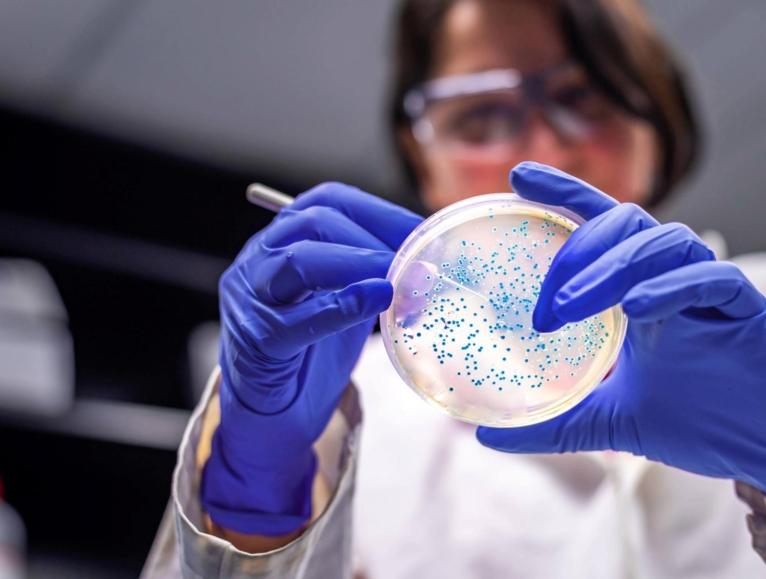
woman looking at micro-organism

Microorganisms
Boost microorganism production with our plant-based, non-GMO fermentation solutions. Ensuring stable biomass, optimized yield, and consistent probiotic quality.
Transform your fermentation process with plant-based innovation
The global microorganisms market is experiencing unprecedented growth, valued at €7.8 billion in 2024 with a 6% CAGR (Compound Annual Growth Rate). As demand for natural, healthy products continues to rise, producers of yeasts, bacteria, fungi, and probiotics face increasing pressure to deliver stable, high-quality biomass at scale while maintaining regulatory compliance.
Whether you're producing probiotics, starter cultures for cheese or meat production, or scaling microorganisms cultivation, Roquette's comprehensive portfolio of plant-based solutions empowers your fermentation success.
Our labs are well-suited to help our customers discover plant-based solutions for optimizing fermentation media for the production and stabilization of probiotic strains. In addition to freeze drying, Roquette also has testing capabilities and solutions for other types of microbial stabilization used across many applications, such as spray drying, fluidized bed drying, cryopreservation, and granulation.
Application Scientist at Roquette
Plant-based solutions for every stage
Our portfolio for microorganisms production delivers complete processing support through plant-based, non-GMO, and non-allergen ingredients, with many meeting food-grade standards. Our solutions are organized into two distinct product categories based on origin and composition (corn, pea, potato, wheat):
Nutritional Solutions
Our nitrogen sources, such as SOLULYS® and NUTRALYS®, provide essential proteins, peptides and amino acids content for primary fermentation nutrition, while also providing growth factors that deliver the complete spectrum of nutrients vital for optimal microorganism development. Carbon sources, like hydrolysates, dextrose and maltodextrins, play a crucial role in providing a stable energy supply, supporting the metabolic activities of microorganisms throughout the fermentation process.
Processing Excellence
We complement our nutritional offerings with specialized processing aids, including advanced filtration solutions that guarantee product clarity and purity. Native starches from peas and potatoes can be effectively used as filtration aids in yeast separation on drum filters, enhancing the filtration process by improving clarity and reducing clogging. Our spray and freeze-drying aids, GLUCIDEX® product range provides critical protection during the drying process, preserving the viability and stability of sensitive probiotic strains while maintaining product integrity from fermentation to final packaging.
This approach ensures that whether you're scaling production, optimizing yield, or maintaining consistent quality standards, Roquette's plant-based solutions support every critical stage of your microorganisms development process.
Deep dive in our Plant-based Solutions for the Fermentation Market
We deliver raw materials to move towards more ustainable production processes
Ready to co-create your next product with us?
Connect with Roquette BioIndustry Experts, to discuss your need